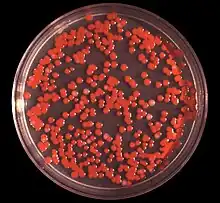

Serratia marcescens
| Serratia marcescens | |
|---|---|
| |
| Serratia marcescens on an agar plate | |
| Scientific classification | |
| Domain: | Bacteria |
| Kingdom: | Pseudomonadati |
| Phylum: | Pseudomonadota |
| Class: | Gammaproteobacteria |
| Order: | Enterobacterales |
| Family: | Yersiniaceae |
| Genus: | Serratia |
| Species: | S. marcescens
|
| Binomial name | |
| Serratia marcescens | |
Serratia marcescens (/səˈreɪʃiə mɑːrˈsɛsɪnz/)[3] is a species of rod-shaped, Gram-negative bacteria in the family Yersiniaceae. It is a facultative anaerobe and an opportunistic pathogen in humans. It was discovered in 1819 by Bartolomeo Bizio in Padua, Italy.[4] S. marcescens is commonly involved in hospital-acquired infections (HAIs), also called nosocomial infections, particularly catheter-associated bacteremia, urinary tract infections, and wound infections,[5][6] and is responsible for 1.4% of HAI cases in the United States.[7] It is commonly found in the respiratory and urinary tracts of hospitalized adults and in the gastrointestinal systems of children.
Due to its abundant presence in the environment, and its preference for damp conditions, S. marcescens is commonly found growing in bathrooms (especially on tile grout, shower corners, toilet water lines, and basins), where it manifests as a pink, pink-orange, or orange discoloration and slimy film feeding off phosphorus-containing materials or fatty substances such as soap and shampoo residue.
Once established, complete eradication of the organism is often difficult, but can be accomplished by application of a bleach-based disinfectant. Rinsing and drying surfaces after use can also prevent the establishment of the bacterium by removing its food source and making the environment less hospitable.
S. marcescens may also be found in environments such as dirt and the subgingival biofilm of teeth. Due to this, and because S. marcescens produces a reddish-orange tripyrrole dye called prodigiosin, it may cause staining of the teeth. The biochemical pathway for the production of prodigiosin by S. marcescens has been characterized by analyzing what intermediates become accumulated in specific mutants.[8]
Identification
S. marcescens is a motile organism and can grow in temperatures ranging from 5–40 °C and in pH levels ranging from 5 to 9. It is differentiated from other Gram-negative bacteria by its ability to perform casein hydrolysis, which allows it to produce extracellular metalloproteinases which are believed to function in cell-to-extracellular matrix interactions. Since this bacterium is a facultative anaerobe, meaning that it can grow in either the presence of oxygen (aerobic) or in the absence of oxygen (anaerobic), it is capable of nitrate reduction under anaerobic conditions. Therefore, nitrate tests are positive since nitrate is generally used as the final electron acceptor rather than oxygen. S. marcescens also exhibits tyrosine hydrolysis and citrate degradation.[9][4] Citrate is used by S. marcescens to produce pyruvic acid, thus it can rely on citrate as a carbon source and test positive for citrate utilization.[4] In identifying the organism, one may also perform a methyl red test, which determines if a microorganism performs mixed-acid fermentation. S. marcescens results in a negative test. Another determination of S. marcescens is its capability to produce lactic acid by oxidative and fermentative metabolism. Therefore, S. marcescens is lactic acid O/F+.[10]

| Test | Result[11] |
|---|---|
| Gram stain | − |
| Oxidase | − |
| Indole production | − |
| Methyl Red | > 70% − |
| Voges-Proskaeur | + |
| Citrate (Simmons) | + |
| Hydrogen sulfide production | − |
| Urea hydrolysis | > 70% − |
| Phenylalanine deaminase | − |
| Lysine decarboxylase | + |
| Motility | + |
| Gelatin hydrolysis, 22 °C | + |
| Acid from lactose | − |
| Acid from glucose | + |
| Acid from maltose | + |
| Acid from mannitol | + |
| Acid from sucrose | + |
| Nitrate reduction | + (to nitrite) |
| Deoxyribonuclease, 25 °C | + |
| Lipase | + |
| Pigment | some biovars produce red |
| Catalase production (24h) | + |
Pathogenicity

In humans, S. marcescens can cause an opportunistic infection in several sites,[12] including the urinary tract, respiratory tract, wounds,[7] and the eye, where it may cause conjunctivitis, keratitis, endophthalmitis, and tear duct infections.[13] It is also a rare cause of endocarditis and osteomyelitis (particularly in people who use intravenous drugs recreationally), pneumonia, and meningitis.[6][7] Most S. marcescens strains are resistant to several antibiotics because of the presence of R-factors, which are a type of plasmid that carry one or more genes that encode resistance; all are considered intrinsically resistant to ampicillin, macrolides, and first-generation cephalosporins (such as cephalexin).[6]
In elkhorn coral, S. marcescens is the cause of the disease known as white pox disease.[14] In silkworms, it can also cause a lethal disease, especially in association with other pathogens.[15]
In research laboratories employing Drosophila fruit flies, infection of them with S. marcescens is common. It manifests as a pink discoloration or plaque in or on larvae, pupae, or the usually starch and sugar-based food (especially when improperly prepared).
A rare clinical form of gastroenteritis occurring in early infancy caused by infection with S. marcescens. The red color of the diaper can be mistaken for hematuria (blood in the urine), which may cause unnecessary investigations by the physicians.[16]
S. marcescens causes cucurbit yellow vine disease, leading to sometimes serious losses in melon fields.[17]
Professor Jim Burritt and his students at the University of Wisconsin-Stout have discovered a new strain of S. marcescens in bee blood (haemolymph) from hives decimated by winterkill. His research findings have been published and the new strain was named sicaria, which means assassin in Latin. The professor states that S. marcescens sicaria "may contribute to the wintertime failure of honey bee colonies".[18][19]
History
Possible role in medieval miracles
Because of its red pigmentation, caused by expression of the dye prodigiosin,[20] and its ability to grow on bread, S. marcescens has been evoked as a naturalistic explanation of medieval accounts of the "miraculous" appearance of blood on the Corporal of Bolsena.[20] This followed celebration of a mass at Bolsena in 1263, led by a Bohemian priest who had doubts concerning transubstantiation, or the turning of bread and wine into the Body and Blood of Christ during the mass. During the mass, the Eucharist appeared to bleed and each time the priest wiped away the blood, more would appear.[20] This event is celebrated in a fresco in the Apostolic Palace in the Vatican City, painted by Raphael.[21]
Discovery
S. marcescens was discovered in 1819 by Venetian pharmacist Bartolomeo Bizio, as the cause of an episode of blood-red discoloration of polenta in the city of Padua.[22] Bizio named the organism four years later in honor of Serafino Serrati, a physicist who developed an early steamboat; the epithet marcescens (Latin for 'decaying') was chosen because of the dyestuff's rapid deterioration (Bizio's observations led him to believe that the organism decayed into a mucilage-like substance upon reaching maturity).[23] Serratia was later renamed Monas prodigiosus and Bacillus prodigiosus before Bizio's original name was restored in the 1920s.[22]
Uses and misuse
Role in biowarfare testing
Until the 1950s, S. marcescens was erroneously believed to be a nonpathogenic "saprophyte",[7] and its reddish coloration was used in school experiments to track infections. During the Cold War, it was used as a simulant in biological warfare testing by the U.S. military,[24] which studied it in field tests as a substitute for the tularemia bacterium, which was being weaponized at the time.
On 26 and 27 September 1950, the U.S. Navy conducted a secret experiment named "Operation Sea-Spray" in which balloons filled with S. marcescens were released and burst over urban areas of the San Francisco Bay Area in California. Although the Navy later claimed the bacteria were harmless, beginning on September 29, 11 patients at a local hospital developed very rare, serious urinary tract infections. One of the afflicted patients, Edward J. Nevin, died.[25] Cases of pneumonia in San Francisco also increased after S. marcescens was released.[26][27] (That the simulant bacteria caused these infections and death has never been conclusively established.) Nevin's son and grandson lost a lawsuit they brought against the government between 1981 and 1983, on the grounds that the government is immune,[28] and that the chance that the sprayed bacteria caused Nevin's death was minute.[29] The bacterium was also combined with phenol and an anthrax simulant and sprayed across south Dorset by US and UK military scientists as part of the DICE trials which ran from 1971 to 1975.[30]
Since 1950, S. marcescens has steadily increased as a cause of human infection, with many strains resistant to multiple antibiotics.[5] The first indications of problems with the influenza vaccine produced by Chiron Corporation in 2004 involved S. marcescens contamination.
Contaminated injectables
In early 2008, the U.S. Food and Drug Administration issued a nationwide recall of one lot of Pre-Filled Heparin Lock Flush Solution USP.[31] The heparin IV flush syringes had been found to be contaminated with S. marcescens, which resulted in patient infections. The Centers for Disease Control and Prevention confirmed growth of S. marcescens from several unopened syringes of this product.
S. marcescens has also been linked to 19 cases in Alabama hospitals in 2011, including 10 deaths.[32] All of the patients involved were receiving total parenteral nutrition at the time, and this is being investigated as a possible source of the outbreak.[33]
Ground-water flow tracing
Because of its ability to be grown on agar plates into even, well coloured lawns, and the existence of a phage specific to S. marscecens, it has been used to trace water flows in Karst limestone systems. Known quantities of phage are injected into a fixed point in the Karst water system and the outflow of interest are monitored by conventional small-volume sampling at fixed time intervals. In the laboratory, the samples are poured onto grown S. marscecens lawns and incubated. Colourless plaques in the lawns indicate the presence of phage. The method was claimed to be sensitive at very high dilutions because of the ability to detect single phage particles.[34][35]
See also
- Eucharistic miracle
- Serratia marcescens nuclease
- Serratia marcescens extracellular proteinase
References
- ↑ Biblioteca italiana, o sia Giornale di letteratura, scienze ed arti (in italiano). 1823. pp. 275–295. Archived from the original on 22 April 2023. Retrieved 11 August 2019.
- ↑ "Genus Serratia". List of Prokaryotic Names with Standing in Nomenclature (LPSN). Archived from the original on 22 February 2020. Retrieved 6 June 2016.
- ↑ Hicks, Randall. "Pronunciation Guide to microorganisms" (PDF). University of Minnesota. Archived (PDF) from the original on 26 August 2014. Retrieved 16 April 2023.
- ↑ 4.0 4.1 4.2 Serratia marcescens. (2011, April). Retrieved from https://microbewiki.kenyon.edu/index.php/Serratia_marcescens Archived 11 April 2019 at the Wayback Machine
- ↑ 5.0 5.1 Hejazi A; Falkiner FR (1997). "Serratia marcescens". J Med Microbiol. 46 (11): 903–12. doi:10.1099/00222615-46-11-903. PMID 9368530. S2CID 12248893. Archived from the original on 22 April 2023. Retrieved 16 April 2023.
- ↑ 6.0 6.1 6.2 Auwaerter P (8 October 2007). "Serratia species". Point-of-Care Information Technology ABX Guide. Johns Hopkins University. Archived from the original on 14 April 2013. Retrieved 13 December 2008.
Freely available with registration.
- ↑ 7.0 7.1 7.2 7.3 Serratia at eMedicine
- ↑ Williamson NR, Fineran PC, Gristwood T, Leeper FJ, Salmond GP (2006). "The biosynthesis and regulation of bacterial prodiginines". Nature Reviews Microbiology. 4 (12): 887–899. doi:10.1038/nrmicro1531. PMID 17109029. S2CID 11649828.
- ↑ Aryal, S. (2018, June 23). Biochemical Test and Identification of Serratia marcescens. Retrieved from https://microbiologyinfo.com/biochemical-test-and-identification-of-serratia-marcescens/ Archived 11 April 2019 at the Wayback Machine
- ↑ "Serratia". Soil Microbiology, Environmental Microbiology BIOL/CEEE/CSES 4684. Virginia Tech. 2004. Archived from the original on 6 April 2005.
- ↑ Bergey's Manuals of Determinative Bacteriology, by John G. Holt, 9th ed. Lippincott Williams & Wilkins, 15 January 1994. p. 217
- ↑ "Pathogen Safety Data Sheets: Infectious Substances – Serratia spp". Public Health Agency of Canada. 30 April 2012. Archived from the original on 24 September 2019. Retrieved 28 April 2018.
- ↑ "Serratia Marcescens seton implant infection & orbital cellulitis". EyeRounds.org. Archived from the original on 22 February 2014. Retrieved 6 April 2006.
- ↑ Patterson KL, Porter JW, Ritchie KB, et al. (June 2002). "The etiology of white pox, a lethal disease of the Caribbean elkhorn coral, Acropora palmata". Proc Natl Acad Sci USA. 99 (13): 8725–30. doi:10.1073/pnas.092260099. PMC 124366. PMID 12077296.
- ↑ Vasantharajan VN, Munirathnamma N (1978). "Studies on Silkworm Diseases III - Epizootiology of a Septicemic Disease of Silkworms Caused by Serratia marcescens". Journal of the Indian Institute of Science. 60 (4). Archived from the original on 17 August 2016. Retrieved 14 July 2016.
- ↑ The Red Diaper Syndrome. Rev Chil Paediatr. 1960 Jul;31:335-9
- ↑ "Cucurbit Yellow Vine Disease (CYVD) In Connecticut". University of Connecticut Integrated Pest Management. Archived from the original on 25 May 2012.
- ↑ "Review of Bee Health Decline » Research buzz: Professor, students identify bacterium that may kill honey bees". www.thecre.com. Archived from the original on 9 April 2023. Retrieved 2 January 2017.
- ↑ "Biology Professor Discovers New Clue About What's Killing Bees". NBC News. Archived from the original on 9 April 2023. Retrieved 2 January 2017.
- ↑ 20.0 20.1 20.2 Bennett JW; Bentley R (2000). "Seeing red: The story of prodigiosin". Adv Appl Microbiol. Advances in Applied Microbiology. 47: 1–32. doi:10.1016/S0065-2164(00)47000-0. ISBN 978-0-12-002647-0. PMID 12876793.
- ↑ "The Mass at Bolsena by Raphael". Vatican Museums. Archived from the original on 30 April 2006. Retrieved 3 May 2006.
- ↑ 22.0 22.1 Sehdev PS; Donnenberg MS (October 1999). "Arcanum: The 19th-century Italian pharmacist pictured here was the first to characterize what are now known to be bacteria of the genus Serratia". Clin Infect Dis. 29 (4): 770, 925. doi:10.1086/520431. PMID 10589885.
- ↑ Bizio's original report was translated into English in 1924, and published in the Journal of Bacteriology. See Merlino CP (November 1924). "Bartolomeo Bizio's Letter to the most Eminent Priest, Angelo Bellani, Concerning the Phenomenon of the Red Colored Polenta". J Bacteriol. 9 (6): 527–43. doi:10.1128/JB.9.6.527-543.1924. PMC 379088. PMID 16559067.
- ↑ "How the U.S. Government Exposed Thousands of Americans to Lethal Bacteria to Test Biological Warfare". Democracy Now!. 13 July 2005. Archived from the original on 14 November 2007. Retrieved 6 June 2016.
- ↑ "Serratia has dark history in region". SFGate. 31 October 2004. Archived from the original on 15 February 2020. Retrieved 14 July 2016.
- ↑ Cole, Leonard A. (1988). Clouds of Secrecy: The Army's Germ-Warfare Tests Over Populated Areas. (Foreword by Alan Cranston.). Totowa, New Jersey: Rowman & Littlefield. ISBN 0-8476-7579-3.
- ↑ Regis, Ed (April 1999). The Biology of Doom : America's Secret Germ Warfare Project. Diane Publishing Company. ISBN 0-7567-5686-3.
- ↑ Cole, Op. cit., pp. 85-104.
- ↑ Cole, Leonard A. (1990). Clouds of Secrecy: The Army's Germ Warfare Tests Over Populated Areas. Rowman & Littlefield. p. 102. ISBN 978-0-8226-3001-2.
- ↑ Barnett, Antony (21 April 2002). "Millions were in germ war tests". The Guardian. Archived from the original on 20 August 2020. Retrieved 27 October 2012.
- ↑ "AM2 PAT, Inc. Issues Nationwide Recall of Pre-Filled Heparin Lock Flush Solution USP (5 mL in 12 mL Syringes)". Archived from the original on 23 December 2007. Retrieved 16 April 2023.
- ↑ Nisbet, Robert (30 March 2011). "Drip Feeds Linked To US Hospital Deaths". Archived from the original on 22 April 2023. Retrieved 31 March 2011.
- ↑ "CDC And ADPH Investigate Outbreak At Alabama Hospitals; Products Recalled". FDA. Archived from the original on 1 April 2011. Retrieved 31 March 2011.
- ↑ Jofre J. Goldscheider N; Drew D (eds.). Methods in Karst Hydrology. International Association of Hydrogeologists -IAWPRC. pp. 138–139.
- ↑ Horan N J; Naylor P J (November 1988). Water Pollution Control in Asia -The potential of bacteriophage to act as tracers of water movement. Pergamon Press. pp. 700–704. ISBN 0-08-036884-0.
Further reading
- Hernandez Marchant R; Oyarce Rojas P; Arcaya O (1960). "The red diaper syndrome. Serratia marcescens infection". Rev Chil Pediatr (in español). 31 (4): 335–9. doi:10.4067/s0370-41061960000400001. PMID 13713665.
External links
- "Serratia marcescens". NCBI Taxonomy Browser. 615. Archived from the original on 17 August 2018. Retrieved 16 April 2023.
- Type strain of Serratia marcescens at BacDive - the Bacterial Diversity Metadatabase Archived 15 May 2018 at the Wayback Machine